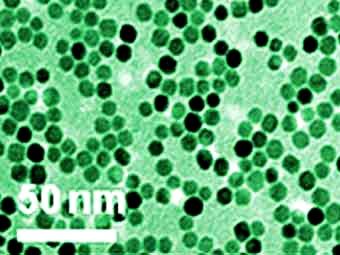
.   ,

|
Использованные авторами работы наночастицы магнетита. Снимок Джон Сяо, университет Делавэра
|
Согласно исследованию, опубликованному в журнале Journal of Environmental Monitoring, наночастицы магнетита могут накапливаться в тканях некоторых растений. Накопившиеся в выращенных на влажной среде тыквах частицы попадут в пищевую цепочку, переходя другим организмам и условия такого накопления нуждаются в дополнительном изучении.
Порошок из гранул магнетита размером меньше десяти нанометров (нанометр - миллионная доля миллиметра) попадал из водного субстрата в ткани выращиваемых исследователями тыкв. При этом мексиканские бобы или выращенные на другом грунте тыквы были менее подвержены эффекту.
Магнетит легко обнаруживался магнетометром в высушенных при помощи вакуумной камеры частях растений. Как утверждает один из авторов исследования, Джон Сяо (John Xiao), этот высокоточный метод позволит продолжить исследования в этой области и дальше.
Также в университетской газете UDaily он говорит, что пока рано поднимать тревогу по поводу полученных результатов. "Мы рассмотрели самый худший случай для того, чтобы проверить саму методику", - сообщается в статье. Тем не менее, вопрос о токсичности
или ином негативном эффекте наночастиц весьма актуален и потому изучение их круговорота в природе представляет значительный интерес.



